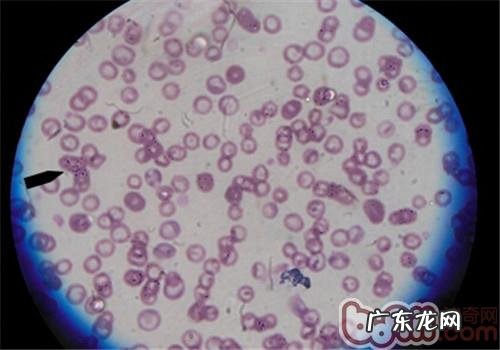
夏天裂头蚴之——蜱

蜱虫针对人们的伤害,常常在新闻报导中出現,那麼蜱虫针对萌宠的伤害也非常大,尤其是在夏天,针对蜱的防止应该是如何的?又也是有这些常见问题?
一、蜱虫的伤害
1.缺铁性贫血
蜱粘附在小宠物的身上饮血时,另外将麻醉药和抗凝剂引入身体,导致饮血口流血不适合被发觉,血夜不凝结,另外蜱的饮血量非常大,各发育阶段吸满血后,容积会变成原先的好几倍至几十倍,导致小宠物丧失过多的血 。
文章插图
血涂片由此可见的巴贝斯虫,是在其中一种虫媒病,腐蚀血细胞
2.传播疾病
蜱粘附在小宠物的身上饮血,蜱虫唾沫里的病源便会进到犬的身体和血夜中,造成 病发 。
根据蜱散播的病症变成蜱媒病,每一年有都是会有很多小宠物因感柒由蜱散播的病症生病,例如巴贝斯虫病,艾利希体病,无形体病及莱姆病 。

文章插图
秋田犬,那时候由于其他病症住院医治,开展全身体格检查时,在其的身上发觉了蜱虫遗体和虱子排泄物 。

文章插图
寻找的蜱虫遗体

文章插图
在另一小宠物的耳朵里面内发觉蜱虫,箭头符号所说为饱血后的蜱虫,有大豆尺寸 。在耳朵里面内的蜱虫容积略小

文章插图
进一步用检耳内镜查验耳朵里面內部,耳内一部分
二、病源介绍
1.归类
蜱虫别名草别子,有硬蜱和软蜱之分 。硬蜱有硬实的角质层薄,男性的角质层薄遮盖全身上下,而雌虫的盾片仅遮盖前三足一部分,腹腔有皱褶,以便其饮血时扩大 。软蜱有皮革制品样的绵软的角质层薄,这种蜱一般仅在安全性的自然环境中主题活动,如小动物的耳孔、洞窟等能出示平稳自然环境的场地 。不一样的蜱,在不一样的寄主,存有寄主拆换状况 。在不一样的地区,蜱虫的类型会出现区别,散播的病症也各有不同 。其发育过程分成卵,幼蜱,若蜱,成蜱 。蜱还能够依据进行一个生活史必须寄主的总数来归类,可分成一寄主蜱,二寄主蜱,三寄主蜱 。一寄主蜱即是从幼蜱至完善维持在一个寄主的身上,二寄主蜱为从第一寄主的身上爆出,从幼蜱退化为若蜱,随后找寻第二寄主,三寄主蜱每一次饮血后均摆脱寄主,在自然环境中退化,每一次退化后找寻新的寄主 。
2.内寄生位置
蜱在寄主的内寄生位置经常出现一定的可选择性,一般在肌肤较薄,不容易被搔动的位置头颈、耳背、腋下、大腿根部、私处和腹股等处 。
三、蜱的生殖力和感召力
雌蜱可汲取本身容积200倍容积的血夜,雌蜱进行血肿后,摆脱寄主,在自然环境中生卵,幼蜱孵化之后爬进绿色植物高空,土壤上感柒小白鼠或是在草地上玩乐的小动物 。
四、医治和预防
1.药品预防
能用梅里亚塞蜱特开展医治和防止 。依据具体情况再做别的解决 。
2.检查身体
每一次户外活动游戏必须对萌宠开展查验,尤其是在蜱主题活动经常的时节 。用手指整理萌宠的头发,略微用劲以保证 可以觉得到肌肤表层的突起 。如果有突起,将头发打开以确定是不是蜱虫 。蜱的尺寸差别非常大,从针管到红提般尺寸都是有 。
3.如何去除蜱虫
用专业的除蜱木梳或是医用镊子,请不要用手指立即将蜱虫出来或是捏死 。
特别声明:本站内容均来自网友提供或互联网,仅供参考,请勿用于商业和其他非法用途。如果侵犯了您的权益请与我们联系,我们将在24小时内删除。
